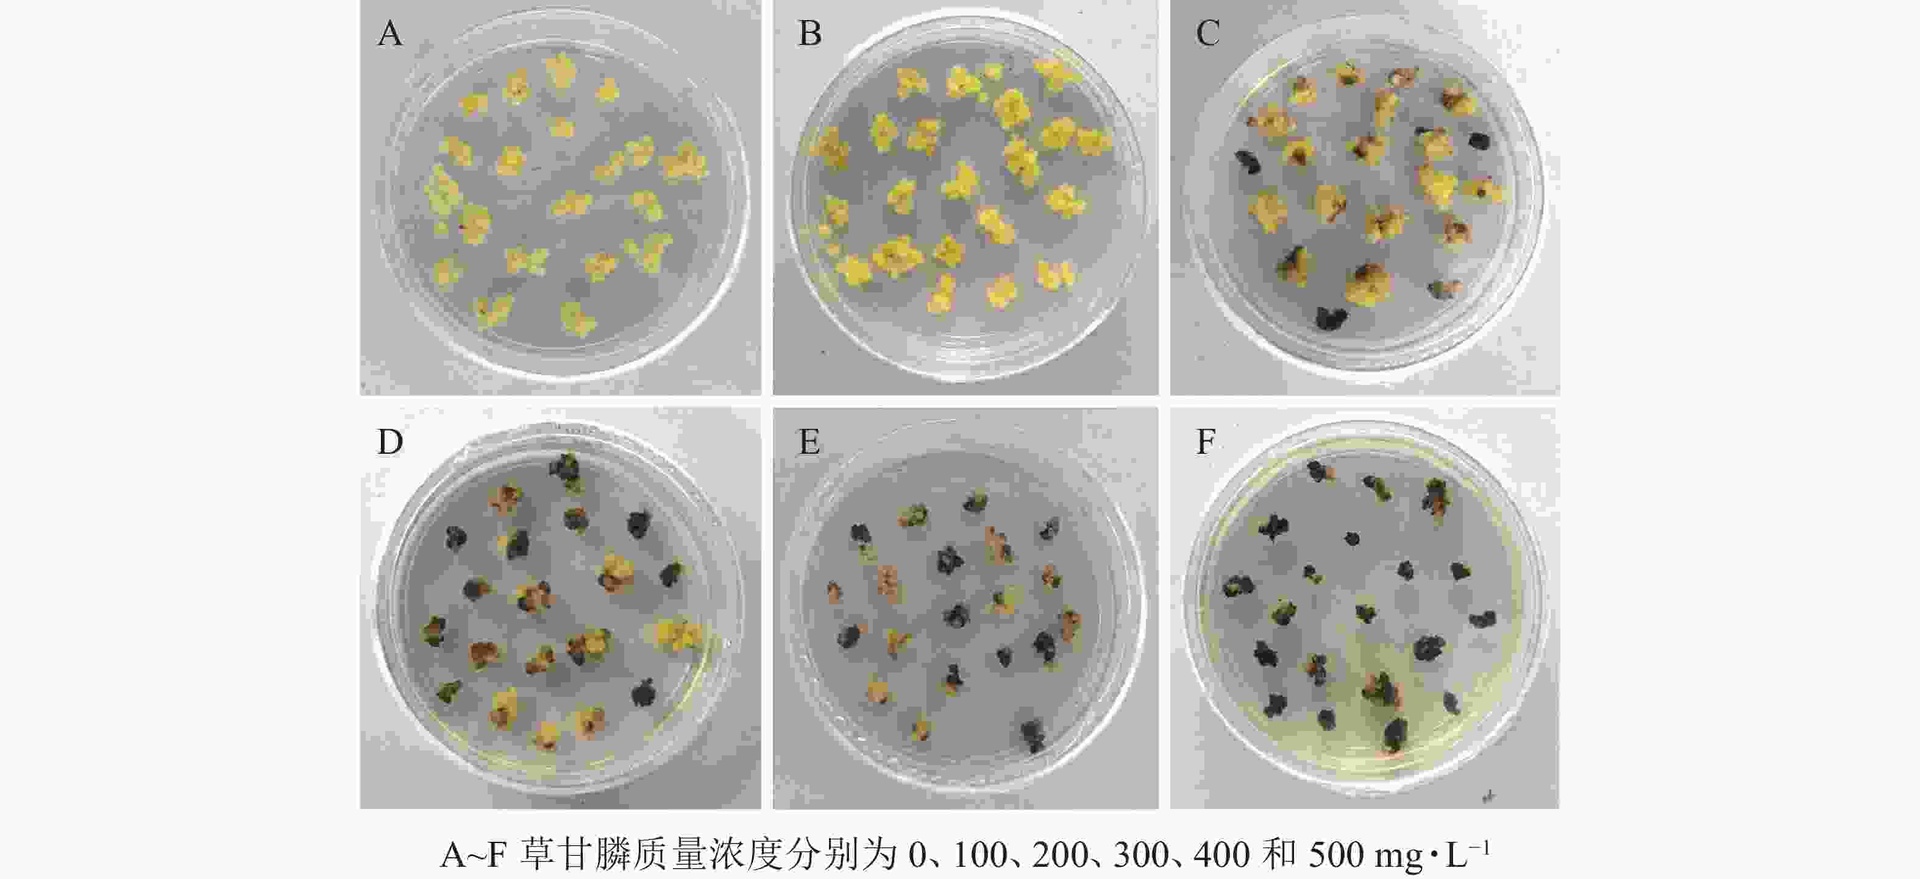
一张科学插图展示草铵膦和草甘膦在植物细胞内的作用靶点:左侧显示草铵膦抑制谷氨酰胺合成酶导致氨积累;右侧显示草甘膦阻断EPSPS酶影响蛋白质合成,细胞结构受损 草铵膦与草甘膦作用机制对比示意图

什么是草铵膦?
草铵膦(Glufosinate-ammonium)是一种广谱、非选择性除草剂,广泛应用于农业、园艺和林业等领域。它通过抑制植物体内的谷氨酰胺合成酶(GS),导致氨的积累,破坏光合作用和能量代谢,最终使杂草枯死。由于其高效、低残留和对环境相对友好的特性,草铵膦近年来在全球范围内的使用量持续上升。
作为一种重要的替代草甘膦的除草剂,草铵膦在抗除草剂作物系统中扮演着关键角色,尤其是在抗草铵膦转基因作物(如玉米、大豆、油菜等)的田间管理中表现突出。

草铵膦是灭生性除草剂吗?
是的,草铵膦是灭生性除草剂。所谓“灭生性除草剂”,指的是能够杀死几乎所有绿色植物的除草剂,不分作物或杂草种类,只要接触到药液且不具备抗性,都会受到伤害甚至死亡。
草铵膦正属于这一类。它不具备选择性,施药后主要通过叶片吸收,迅速传导至整株植物,造成不可逆的生理损伤。因此,在使用过程中必须严格避免药液飘移到邻近的敏感作物上,否则会造成严重药害。
值得注意的是,虽然草铵膦本身是灭生性的,但在实际农业生产中,常与抗草铵膦的转基因作物配套使用。这类作物经过基因改造,能够在体内分解草铵膦毒素,从而实现“选择性除草”的效果——即保护作物、杀灭杂草。
与其他灭生性除草剂的比较
草铵膦常被拿来与另一种主流灭生性除草剂——草甘膦(Glyphosate)进行对比。两者虽然都属于非选择性除草剂,但在作用机制、降解速度和抗性发展方面存在显著差异。
- 作用机制不同:草甘膦主要抑制芳香族氨基酸合成途径中的EPSPS酶,而草铵膦则作用于谷氨酰胺合成酶。
- 见效速度更快:草铵膦通常在施药后2–5天内即可看到明显枯萎症状,而草甘膦可能需要7天以上。
- 土壤残留低:草铵膦在土壤中降解较快,半衰期短,不易产生累积毒性,对后茬作物影响较小。
- 抗性问题较轻:相较于广泛使用导致抗性杂草频发的草甘膦,草铵膦的抗性发展相对较慢,仍是许多地区防控抗性杂草的重要工具。
使用注意事项与安全建议
尽管草铵膦具有诸多优势,但作为灭生性除草剂,其使用仍需遵循严格的规范:
- 避开风力较大时段施药,防止药液漂移造成邻近作物受害;
- 使用专用喷头,减少雾滴细小带来的飘散风险;
- 穿戴防护装备,包括手套、口罩、护目镜等,保障操作人员安全;
- 避免在高温强光下施药,以提高药效并减少蒸发损失;
- 轮换用药策略,结合其他作用机制的除草剂,延缓抗性发展。
此外,虽然草铵膦对哺乳动物毒性较低(属低毒级),但仍需妥善储存和处理,避免污染水源和生态环境。
实际应用场景举例
草铵膦广泛用于果园行间除草、茶园清园、免耕播种前的杂草清除、道路边坡绿化管理以及工业区防草等场景。例如,在柑橘园中,果农可在树行之间定向喷雾草铵膦,有效控制杂草而不伤及果树主干(前提是不喷到嫩叶或新梢)。
同时,随着抗草铵膦作物的推广,该药剂在玉米、棉花、甜菜等大田作物中的应用也日益增多,成为现代农业可持续杂草管理的重要组成部分。

结论
综上所述,草铵膦确实是灭生性除草剂,具备广谱、快速、低残留的优点。正确理解“草铵膦是灭生性除草剂吗”这一问题,有助于农户科学合理地使用该药剂,发挥其最大效益的同时规避潜在风险。未来,随着抗性管理和绿色农业的发展,草铵膦将在综合杂草防控体系中继续发挥重要作用。